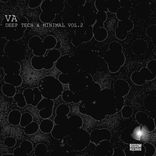
Wide Wave

Wide Wave (Original Mix)
Artiest:
Label:Bosom
Releasedatum:08 mei 2018
Catalogus:VABR027
Genre:Tech House
Duur:7:37
Tempo:127 BPM
Toonsoort:F minor
ISRC:GBKQU1793543
Wij, Volumo, zijn de verantwoordelijke voor jouw persoonsgegevens en gebruiken cookies om inhoud en advertenties te personaliseren, om sociale mediafuncties aan te bieden en om ons verkeer te analyseren. We delen ook informatie over je gebruik van onze website met onze sociale media-, advertentie- en analysepartners die deze kunnen combineren met andere informatie die je aan hen hebt verstrekt of die ze hebben verzameld vanuit jouw gebruik van hun diensten.